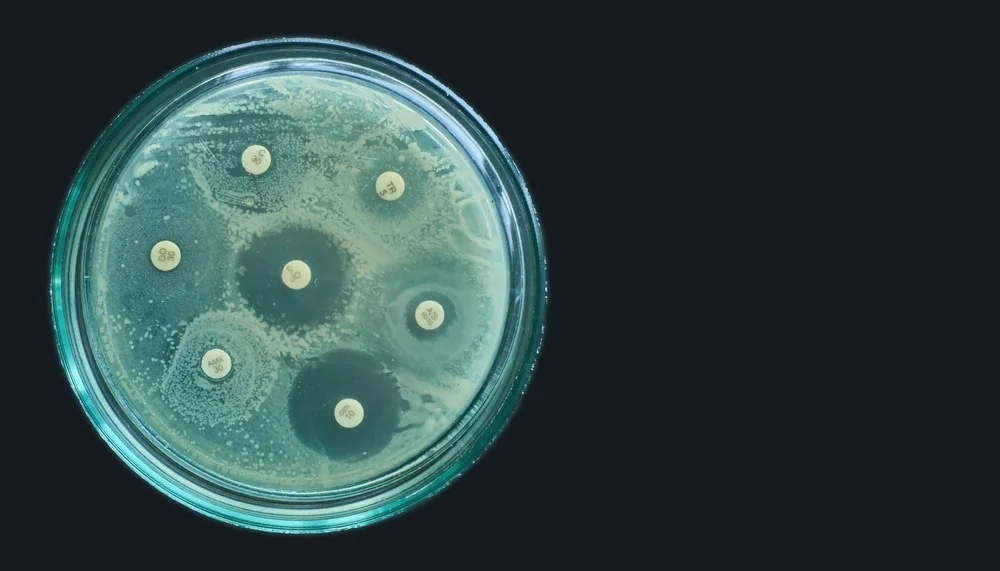

Sponsor
How to Bet Responsibly and Avoid Gambling Risks
Online betting has revolutionized the gambling industry, which makes it more accessible than ever. Previously, bettors had to go to physical casinos or bookmakers to position their wagers. However, with the advancement of technology, online betting platforms have emerged, allowing visitors to gamble from the comfort of the homes. Today, countless users worldwide engage in online betting, whether for sports, casino games, and other kinds of wagers. The convenience of mobile apps and websites has further fueled this growth, making online betting a booming industry with billions in revenue.
One of many main reasons for the success of online betting is its numerous advantages over traditional betting. First and foremost, online betting offers unmatched convenience. Players no more need certainly to travel to an actual location to position their bets. Instead, they can access betting sites anytime, anywhere, utilizing their smartphones or computers. Additionally, online betting platforms give a wider selection of options, including sports betting, live betting, casino games, poker, and even esports wagering. The accessibility to bonuses and promotions also makes online betting more appealing, as players can make the most of free bets, deposit bonuses, and cashback offers.
With a large number of online betting sites available, selecting the most appropriate platform may be overwhelming. The main element factors to think about include the site's reputation, security measures, payment options, and available betting markets. A trustworthy betting site needs to have a valid gambling license from recognized authorities, like the UK Gambling Commission or the Malta Gaming Authority. Security is another crucial aspect, as users need to make certain their personal and financial information is protected. Additionally, the most effective betting sites offer a wide range of payment methods, including bank cards, e-wallets, and even cryptocurrency, to cater to different user preferences.
Technology has played an essential role in shaping the internet betting industry. From advanced algorithms that calculate betting odds to AI-powered customer support Learn more, innovation continues to enhance the user experience. Live betting, for instance, allows players to put wagers in realtime as events unfold, adding a fresh level of excitement to sports betting. Moreover, mobile betting apps have managed to get easier for users to position bets on the run, ensuring they never miss an opportunity. Additionally, blockchain technology and cryptocurrencies are making betting more transparent and secure, reducing the risks of fraud and enhancing trust among users.
Successful online betting needs a good knowledge of betting odds and strategies. Betting odds determine the potential payout of a bet and vary with respect to the bookmaker. There are several types of odds, including fractional, decimal, and moneyline, and understanding how they work is required for making informed bets. Additionally, players can use various strategies to improve their chances of winning, such as for example value betting, matched betting, and bankroll management. By carefully analyzing statistics, trends, and expert predictions, bettors could make smarter decisions and enhance their overall success rate.
dustry|the|a} also faces challenges, such as concerns over match-fixing and illegal betting activities, which regulators continue to address.
Categorii
Citeste mai mult
The antimicrobial polymer films market is witnessing dynamic growth fueled not only by technological advancements and increasing demand but also by strategic partnerships and mergers and acquisitions (M&A). These collaborative and consolidative moves are pivotal in expanding product portfolios, enhancing research capabilities, entering new markets, and driving innovation across the...
Advanced cleaning solutions are increasingly crucial in the fast-paced industrial and corporate environment of now. Warehouses, factories, shopping malls, airports, and enormous public areas depend on effective equipment that guarantees both durability and cleanliness. Responding to these contemporary demands, DynaClean Industries proudly presents its creative Ride On Sweeper DRS-180T, a device...



